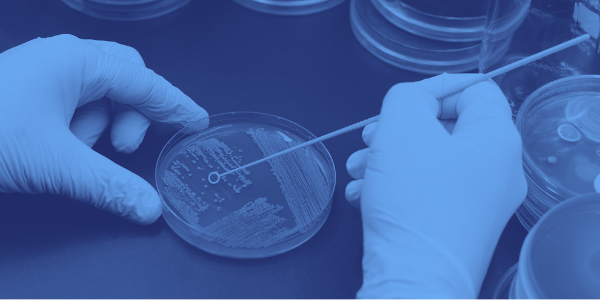

Managing Legionella Risk: Why the Right Lab Partner Matters Managing Legionella risk is a high-stake...


Managing Legionella Risk: Why the Right Lab Partner Matters Managing Legionella risk is a high-stake...
Think Your Microbiological Testing of Your Water System Is FDA Compliant?

Following our previous blog and webinar, "Validation of Alternative Methods for Larger Test Portion ...

This post is a follow-up to our July 2024 blog, Understanding the Fundamental Principles of the ST10...


What a week it was at the AOAC INTERNATIONAL Annual Meeting! The annual event, held this year in Bal...

.png)
During the second half of 2023, the Association for the Advancement of Medical Instrumentation (AAMI...
.png)

United States Pharmacopeia (USP) published a new microbiology test method, USP <60> Tests for Burkho...
Offering comprehensive microbiology and analytical chemistry testing services to the food, pharmaceutical, and personal care industries since 1966.